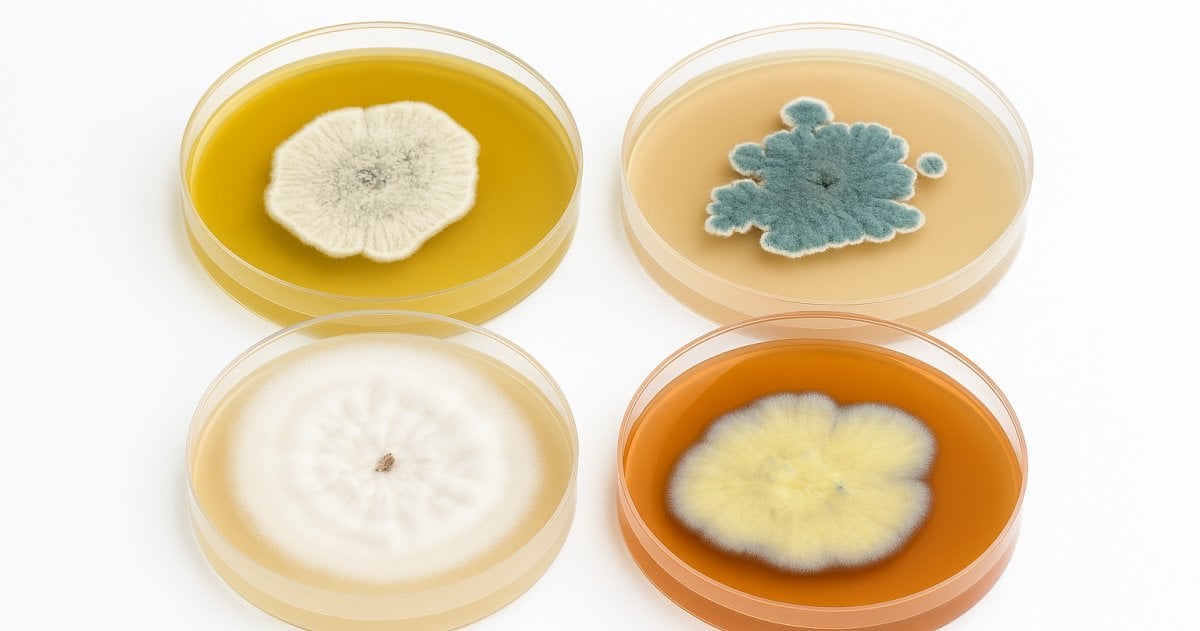
Vier flache Plastikschalen, auf denen verschiedenfarbige Schimmelpilzkulturen wachsen.

What is Hackers' Pub?
Hackers' Pub is a place for software engineers to share their knowledge and experience with each other. It's also an ActivityPub-enabled social network, so you can follow your favorite hackers in the fediverse and get their latest posts in your feed.




 🕊️
🕊️ 









 @技術・雑談
@技術・雑談